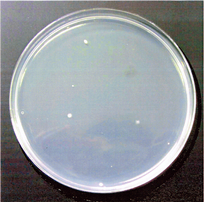

世界初MRI対応ウイッグ 『G-108』
「ウィッグによる医療事故」を防ぎます。
着けたまま、MRIの検査を受けられます。空港の検知器の電磁波にも反応しません。ウィッグ製作半世紀、安心の職人仕上げです。

強磁性体金属は、吸い込まれて事故の原因に…… MRI検査時の吸引や火傷を解消し、国内185万人のがん患者さまの安全を守ります。

-
医療現場の声
- 増毛パウダーがガントリーに飛散する事故が発生した。
- 患者さまがウィッグの金属部分で頭部に火傷することがあった。
-
患者さまの声
- 脱毛した頭部を見られるのがはずかしい。
- ウィッグの中に金属が縫い込まれていることを知らなかった。
当社ウィッグ3つの特徴
Features
ウィッグ製作半世紀のノウハウを集結。
使い心地・品質を保ちながら、医療現場でも信用される商品を開発しました。
-
Point1
常に108種類以上の製品をストック実際に製品を手に取っていただきながら、お客さまの希望に沿った素材や形を選ぶことができます。『すぐに使いたい』という方にも、その場でスタイルを合わせ、即日納品が可能です。

-
Point2
丁寧なメンテナンスで長持ち定期的にウィッグのシャンプー、セットのメンテナンスをいたします。メンテナンスは即日可能。余分なカツラを用意する必要もありません。ご自宅で利用できる、専用シャンプーなどもご用意しています。

-
Point3
手頃な価格とオープンな料金メニューウィッグの価格は不明瞭で心配とお感じの方のために、オープンな料金メニューを提示しています。表示以外の金額は一切かかりません。また、ご予算やお支払方法などもお客さまに合わせて対応いたします。

お客さまが選べる3つの商品
Product
-
既製品 108種類から選ぶ
即日納品
108種類の中からサイズ(S・M・L)・スタイル(6種類)・カラー(4色)をお選びいただきます。お急ぎの方には即日(1時間~2時間程度)お仕上げいたします。
-
セミオーダー
3週間納品
サイズ(S・M・L)を基準に、スタイルや色、毛量にいたるまで、既製品より、さらに細かくご希望にお応えいたします。
-
フルオーダー
1週間納品
頭の採寸をして、お客様にピタリと合わせ、毛の色や材質など細部に至るまでご希望にそって製作いたします。
お客さまのお話を一対一で丁寧にお伺いしながら、ご希望やご予算に合ったカツラを選び、職人の手で自然なスタイルになるように仕上げます。
『G-108』の清潔性と安全性の証明
Proof
ウィッグの本質「毛」へのこだわり医療用に適したオリジナルの人工毛
G-108 の清潔性と安全性の証明
1082の医療用に使用しているTOF特殊ファイバーの衛生結果
「TOF人工毛ポリエステル糸」及び「人毛」を右のように、同じ条件で二週間使用したサンプルに対して、シャーレー雑菌・細菌培養検査を一週間実施しました。
検査結果を比較したところ、人毛は、TOF人工毛ポリエステル糸に対して、500倍の雑菌が付着していることが判明しました。
熱に強く・速乾性が高い「TOF人工毛ポリエステル糸」が最も医療用に適している事がわかりました。
検査協力:メディカル研究所
TOF人工毛ポリエステル糸雑菌培養検査
-
TOF人工毛ポリエステル糸100%使用。
抗菌剤:未使用TOF人工毛ポリエステル糸、湿気を含まず速乾性が高く雑菌・細菌が付きにくい。TOF人工毛ポリエステル糸に抗菌剤を塗布すると、100%近く除菌可能。耐熱温度は180℃。
-
人毛雑菌培養検査
-
人毛100%使用。
抗菌剤:未使用人毛は湿気を含み、乾きにくく、タンパク質のため、雑菌・細菌の温床となり、ニオイを発し不快感を与える。乾燥させるのにドライヤーを長時間当てる必要があり、毛の根元と毛先がVの字に同じ本数の植毛するため、キューティクルが逆になり、シャンプーの時は、長い時間をかけて、上手くとかさないと髪の毛がダンゴになり、使用できなくなる恐れがある。
-

自由に移動できるオリジナルピン
Original pin
当社のオリジナル移動式ピンは、地毛や皮膚を傷めることなく、自由なところに装着することができます。ピンの個数を増減することができ、装着時に外れることへの不安を解消します。 ピンはチタン製を使用。チタンは加工が難しく、トウハツが理想とするピンを形成するために、いくつもの国内加工業者をまわりました。こだわりをもつ工場との出会いを経て、何度も試作を繰り返し、最終的に丈夫でしなやかなピンを実現させました。
ピン位置を定期的に移動させることで、ピンによる二次的脱毛を防ぎます。
『G-108』開発について
development
-MRI検査時の事故やケガを解消し、国内185万人のガン患者さまの安全を守りたい-
そう思ったのが、開発のきっかけです。
ウィッグによるMRIの事故を知り新商品の開発をスタート
MRI検査の際、装着したまま検査出来る新しいウィッグ『G-108』を着想したのが5年前です。大学病院の先生からウィッグがMRIに吸引された事故をお聞きし、関連の情報を調べた結果、その事実に驚きました。
さらに様々な文献や現場の声を調べていくうちにこの件数は氷山の一角と言うことが判明しました。 ウィッグを本業としている弊社にとっては、千歳一隅のチャンスと思い、早速開発をスタートしました。埼玉県の産業試験場では、どの様な素材が非磁性を持っているか、リン青銅やアルミニウムなどで試作品をつくりましたが失敗に終わりました。
調査の結果、チタニウムが適していることがわかり、全国のチタニウム加工所を探しました。依頼したときは「出来ますよ」と言われましたが、いざ試作を進めてみると、全国16社の加工工場すべてで「やはり難しい」と断られました。
理由としては、チタニウムは大型の板や棒の加工は簡単に出来るが、小物では、曲げ加工や絞り加工をするには素材が硬過ぎるため、反転性能がきかず、ひび割れをしてしまうためでした。ちなみにインプラントのような、釘状な物の加工は簡単に出来るそうです。
諦めかけていたところ、日本で唯一チタニウム加工が出来るという、小さな町工場を紹介されました。こだわりは強いですが、頼りになる社長が親身になって相談にのってくれ、「この形態では難しいので、形態を変更する必要がある」との回答をいただきました。
この形態をどの様に変えたら良いか、当社のサンプルを持参して検討したところ、「蝶羽式」で出来そうだということになりました。0.3㎜の厚さのチタニウム合金では割れる可能性があるので、他の種類の素材を混合して製作しようということになりました。
試行錯誤を重ねようやく試作品が完成しました。完成した試作品を用いて、実際のMRI装置で様々な科学的実験を行い結果を論文としてまとめました。年明けの2021年1月半ばに、開発は「成功」と結論を出しました。5年の苦労が一瞬にして報われた瞬間でした。
医療用チタンピン
-
『G-108』ウィッグは装着したままMRIに入り検査が可能です。使われている金属は、すべて純チタン製です。 「3.0T-MRI」装置における吸引力のテストでは、吸引力はほとんど受けませんでした。
ファントムによる実験でわずかに金属アーティファクトが認められましたが、MRI装置における発熱テストでは、純チタン製ピンに問題となる発熱はありませんでした。
-

医療用ウィッグへの想い
thought
1082[トウハツ] のビジョン
MRI検査を受けるたびに問診表に「ウィッグは不可」とあります。
ほとんどのウィッグには強磁性体の金属が埋め込まれていてMRI機器の強力な磁場に吸着してしまったり、患者様が火傷をしてしまう可能性があることが分かりました。
では、なぜトラブルが起きるのでしょうか?
ウィッグの中にはピンの他にも金属部品が縫いこまれているため本人にも分からないケースがあるのです。
磁場発生室に入って、はじめて吸着や火傷のトラブルに合い、その事実を知ることになります。医療機関のウィッグによるトラブル解決するために5年の歳月をかけて研究開発に成功した非磁性製品が「G-108」です。着けたまま検査ができる世界初のウィッグです。
「G-108」は現在、製品の意匠権・特許権を申請中です。チタニウム製(医療用製品=脳腫瘍のクリップ・ステント・歯科用のインプラントなど)として、種々の医療用製品と同様の素材であるため安心してご利用いただけます。
また、医療従事者に正確な情報を伝える事を目的に安全カードを作成しました。検査前に医療従事者に提示することで装着したままMRI検査を受けられる仕組みも考案し、著作権を申請しています。
(但し、検査目的や検査内容によっては、医療機関の判断でウィッグを外した状態で検査を実施する場合もあります。)
癌(がん)・怪我(けが)・火傷(やけど)、医療用ウィッグをご利用される方々の事情は様々です。
おしゃれ用ウィッグの製造からスタートした当社は、医療用としてご利用されるお客様が増える現在、様々なご意見を頂戴し問題解決に取り組んで参りました。
その一つの答えがG-108(非磁性チタン製ピン)です。
医療現場におけるウィッグの使用がご利用者様の不安とならないためにも製品の供給・開発に今後も取り組んで参ります。


